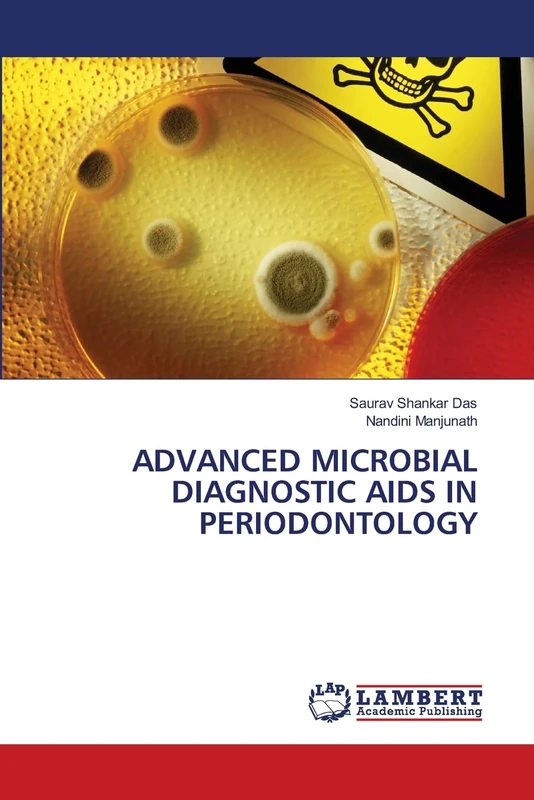
Advanced Microbial Diagnostic AIDS in Periodontology

We can't find the internet
Attempting to reconnect
Something went wrong!
Hang in there while we get back on track

£76.00
LAP Lambert Academic Publishing Periodontal Pathogens
Price data last checked 103 day(s) ago - refreshing...
We'll watch every seller, every day. One email when your price arrives.
It has never been this cheap. We have no record of a lower price.
£76 today · cheaper than every other day in the last 24 months
NEW HERE?
Amazon shows you one price. We show you all of them.
Tosheroon watches Amazon prices so you don't have to. Every product on Amazon has a price history — we make it visible. Set the price you'd actually pay, and we'll email you the second it gets there. No app, no account, one email.
WHAT'S ON THIS PAGE
when this has been cheap or pricey
where the price is heading next
all-time high & low, recent range
name your number, we'll email you
Price History & Forecast
Grey patches = out of stock. Cheaper = lower on the chart. Hover for exact prices.
Last 628 days • 628 data points (No recent data available)
Price Distribution
Price distribution over 628 days • 1 price levels
Price Analysis
Most common price: £76 (628 days, 100.0%)
Price range: £76 - £76
Price levels: 1 different prices over 628 days
Product Specifications
- Format
- Paperback
- ASIN
- 6203853887
- Domain
- Amazon UK
- Release Date
- 23 April 2021
- Listed Since
- 18 May 2021
Barcode
No barcode data available
Similar Products You Might Like

Periodontal Medicine
LAP Lambert Academic Publishing

Bacterial Complexes in Periodontal Diseases
LAP Lambert Academic Publishing

Evidence Based Periodontal Therapy
LAP Lambert Academic Publishing

Controversies in Periodontal Therapy
LAP Lambert Academic Publishing

Periodontal Medicine: An Oral Systemic Interrelationship
LAP Lambert Academic Publishing

Periodontal Medicine: A new paradigm
LAP Lambert Academic Publishing

Role of Inflammation in Periodontal Diseases
LAP Lambert Academic Publishing

Essential Periodontal Instruments: From Basics to Advanced
LAP Lambert Academic Publishing

Periodontal Therapy: Rational sequence of Periodontal Procedures
LAP Lambert Academic Publishing

Interdisciplinary Considerations in Periodontology
LAP Lambert Academic Publishing

Periodontal Medicine: Gums Health & Your Body Relationship.
LAP Lambert Academic Publishing

The Complement System and Periodontal Diseases
LAP Lambert Academic Publishing

Assessment of Periodontal Disease among patient with Systemic Disease: Periodontal disease and systemic conditions: a bidirectional relationship
LAP Lambert Academic Publishing

Current concepts in the Periodontal Regeneration
LAP Lambert Academic Publishing

Periodontal Diagnostic Markers: A Literature Review
LAP Lambert Academic Publishing

Non Surgical Periodontal Therapy: Comprehensive Review
LAP Lambert Academic Publishing

GINGIVAL AND PERIODONTAL CONDITIONS IN CHILDREN
LAP Lambert Academic Publishing

Microbial Etiology of Chronic Periodontitis: A Case-control study
LAP Lambert Academic Publishing

Beyond Boundaries: Integrating Periodontics with Other Disciplines
LAP Lambert Academic Publishing

Metabolic Syndrome and Periodontal Disease
LAP Lambert Academic Publishing

Bone Biomarkers in Periodontal Disease - an update
LAP Lambert Academic Publishing

Roles of Viruses in Periodontology
LAP Lambert Academic Publishing
Advanced Microbial Diagnostic AIDS in Periodontology
LAP Lambert Academic Publishing

Periodontal Plastic Surgery: Refining Soft Tissue Aesthetics and Function in Periodontal Plastic Surgery.
LAP Lambert Academic Publishing